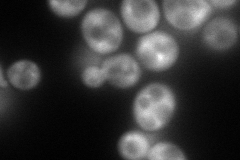
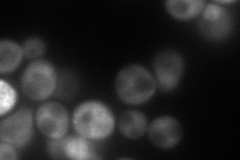
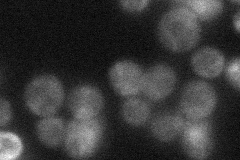
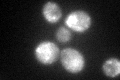

View description
Polyphosphatidylinositol phosphatase, dephosphorylates multiple phosphatidylinositols; involved in trans Golgi network-to-early endosome pathway; hyperosmotic stress causes translocation to actin patches; contains Sac1 and 5-ptase domains
Localization:
Intensity:
Fold change:
Significance:
-
C’ GFP library in SD

punctate47.25 -
N' NOP1pr-GFP in SD
cytosol152.72 -
N' TEF2pr-mCherry in SD
cytosol112.414 -
N' NATIVEpr-GFP in SD
cytosol23.6178 -
N' TEF2pr-VC and Cyto-VN in SD

cytosol73.2366 -
C’ GFP library in SD+DTT
punctate45.930.97No -
C’ GFP library in SD+H2O2

punctate54.681.15No -
C’ GFP library in Starvation Media

punctate49.131.03No -
C’ GFP library on the background of Pup2-DaMP

punctate -
C’ GFP library on the background of CCT mutant

punctate53.96911.14186No
